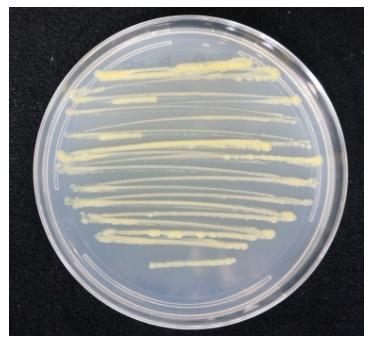

?농촌진흥청은 유기인계 살충제 7종을 분해할 수 있는 미생물을 토양에서 발견했다. 유기인계 살충제는 세계적으로 가장 많이 사용하는 살충제로 100종 이상이 상용화돼 있다.
??유기인계 살충제는 현재 사용 금지된 DDT 등 유기염소계 살충제2)에 비해 독성과 잔류성은 낮으나 오·남용할 경우 작물과 토양에서 검출될 수 있다.
?이번에 발견된 미생물 '스핑고비움 Cam5-1' 균주는 유기인계 살충제 7종을 분해하는 것으로 확인됐다.7종의 살충제는 국내에서 사용 중인 에토프로포스, 카두사포스, 펜토에이트, 포레이트, 포스티아제이트, 프로페노포스 등 6종과 현재 사용하지 않는 말라티온 등 1종이다. 액체 배지에 녹인 살충제에 스핑고비움 Cam5-1 균주를 처리한 결과, 살충제 종류에 따라 빠르게는 1시간에서 길게는 196시간 이내에 63∼100%가 분해됐다. 또한 이 균주를 살충제 카두사포스가 남아 있는 토양에 접종했을 때 2일 만에 살충제가 완전 분해됐다. 균주를 접종하지 않은 토양에서는 살충제가 분해되는데 30일 이상 걸렸다. 세계적으로 1종의 살충제를 분해하는 미생물은 알려져 있으나 여러 종의 살충제를 모두 분해하는 경우는 이번에 발견된 스핑고비움 Cam5-1 균주가 처음이다.
?농촌진흥청은 이번에 발견한 균주와 관련된 연구 결과를 국제학술지인 International Biodeterioration & Biodegradation 132호에 게재했다.
?농촌진흥청 농업미생물과 김남정 과장은 "이 기술을 활용하면 토양에 남아 있는 농약을 효과적으로 제거해 의도하지 않게 농약이 혼입돼 친환경인증이 취소되는 문제 등을 막을 수 있으며, 토양 생태계 보존에도 도움이 될 것이다."라며, "앞으로 화학농약을 분해하는 미생물과 함께 잔류농약 분해를 위한 복합미생물제제도 개발할 계획이다."라고 말했다.
-
글쓴날 : [2019-01-15 11:04:06.0]
Copyrights ⓒ 미디어타임즈 & mdtimes.kr, 무단 전재 및 재배포 금지